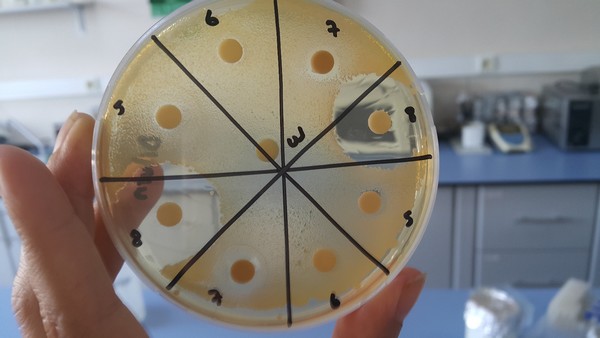
23012026 2 0011

BİROL GÜNGÖRDÜ / ÇANAKKALE – BHA
Çanakkale Onsekiz Mart Üniversitesi (ÇOMÜ), yerli ve çevre dostu teknolojiler alanında önemli bir başarıya daha imza attı. Üniversite bünyesinde geliştirilen çay özü temelli doğal dezenfektan solüsyonu, Türk Patent ve Marka Kurumu’nun 28 Aralık 2025 tarihli kararıyla patent almaya hak kazandı.
2017/19941 numaralı patent başvurusunun sahibi ÇOMÜ Rektörlüğü olurken, buluşun geliştiricileri Dr. Öğr. Üyesi Dilvin İpek ve Prof. Dr. Nükhet Zorba olarak kayıtlara geçti. Akademik bilgi birikiminin somut bir teknoloji çıktısına dönüştüğü bu çalışma, aynı zamanda Türkiye’nin yeşil teknoloji vizyonuna güçlü bir katkı sunuyor.
Patent alan buluşun ilham kaynağı, Anadolu’da kuşaktan kuşağa aktarılan geleneksel iyileşme yöntemleri oldu. Özellikle annelerimizin, gözde çıkan arpacık gibi rahatsızlıklarda demlenmiş çayı kompres olarak kullanması, bu kez bilimsel bir merakın kapısını araladı.
Gündelik hayatta basit bir alışkanlık gibi görünen bu uygulama, ÇOMÜ’lü akademisyenler tarafından laboratuvar ortamında ele alınarak, doğal ve etkili bir dezenfeksiyon teknolojisine dönüştürüldü.
Buluşun çıkış sürecini anlatan Dr. Öğr. Üyesi Dilvin İpek, çalışmanın kültürel hafıza ile bilimsel yöntemi bir araya getirdiğini vurguladı:
“Anadolu kültüründe bitkilerle doğal iyileşme yaklaşımı çok güçlüdür. Biz bu kültürel mirası bilimsel yöntemlerle yeniden ele aldık. Çayın günlük hayattaki sıradan bir kullanımından yola çıkarak, endüstriyel ölçekte karşılık bulabilecek doğal bir dezenfektan fikrini olgunlaştırdık.”
Çalışmanın yalnızca “doğal” olmakla sınırlı kalmadığını belirten Prof. Dr. Nükhet Zorba ise geliştirilen formülasyonun bilimsel ve endüstriyel açıdan güçlü bir altyapıya sahip olduğunun altını çizdi:
“Bu çalışma, yalnızca bitkisel bir ürün geliştirmek amacıyla yapılmadı. Etkinliği ölçülebilen, standardize edilebilen ve farklı alanlarda kullanılabilecek bir yeşil teknoloji ortaya koymak için yürütüldü. Patentle birlikte akademik bilgi, somut bir teknoloji çıktısına dönüştü.”
Araştırmanın uluslararası boyutu ise Güney Kore ile kurulan iş birlikleri sayesinde şekillendi. Çay özünün farklı uygulama alanları üzerine çalışan Prof. Kweon ve Waterlab ekibiyle kurulan temaslar, çalışmanın kapsamını genişletti.
Dr. Öğr. Üyesi İpek, bu sürecin araştırmaya yeni bir vizyon kazandırdığını belirterek şunları söyledi:
“Çay özünün evsel su hatlarında temizlik amacıyla kullanımına yönelik çalışmalar yapan Prof. Kweon ve Waterlab ekibiyle yollarımızın kesişmesi, bu fikrin daha büyük bir potansiyele sahip olduğunu gösterdi. Bu etkileşimle araştırmalarımızı derinleştirdik.”

Araştırma sürecinde 50’den fazla farklı bileşen, gerçek üretim hatlarından elde edilen dirençli mikroorganizmalar üzerinde test edildi. Yapılan deneyler sonucunda boraksın, çay özünün etkinliğini belirgin biçimde artırdığı tespit edildi. Özellikle paslanmaz çelik yüzeylerde elde edilen sonuçlar dikkat çekti.
Patent dokümanında yer alan formülasyon; çay bitkisinden elde edilen epigallokateşin gallat (EGCG) temelli ekstraktın, boraks ve EDTA gibi bileşenlerle belirli oranlarda bir araya getirilmesine dayanıyor.

Çalışmanın temelleri, 2017 yılında tamamlanan doktora tezi sürecinde atıldı. 08 Aralık 2017 tarihinde yapılan patent başvurusu; bilimsel, teknik ve hukuki değerlendirmelerin ardından Aralık 2025’te tescil edilerek sonuçlandı.
Prof. Dr. Zorba, bu uzun sürecin önemine dikkat çekerek şu değerlendirmede bulundu:
“Patent süreçleri yalnızca bilimsel doğrulamayı değil, teknik yeterliliği ve hukuki değerlendirmeyi de içerir. Bu nedenle zaman alabilir. Biz bu süreçte teknolojinin uygulanabilirliğini sürekli geliştirdik.”

Araştırma ekibi, doğal dezenfektanın özellikle gıda güvenliği, gıda hijyeni ve su kaynaklarının korunması açısından büyük bir potansiyel taşıdığını belirtiyor. Çalışmalar kapsamında, Hepatit A gibi gıda kaynaklı patojenlerle ilişkili etkenlere karşı elde edilen sonuçların umut verici olduğu ifade ediliyor.
Dr. Öğr. Üyesi Dilvin İpek, geliştirilen teknolojinin vizyonunu şu sözlerle özetledi:
“İklim değişikliği ve su kıtlığı, artık küresel bir gerçek. Bu doğal dezenfektan ile suyu kirletmeyen, arıtma yükünü azaltan ve endüstriyel atık maliyetlerini düşüren bir çözüm sunmayı hedefliyoruz. Aynı zamanda Türkiye’nin Sıfır Atık yaklaşımıyla uyumlu, ölçeklenebilir bir yeşil teknoloji geliştirdik.”
Geliştirilen formülasyonun; gıda sanayi, evsel kullanım, hastane hijyeni ve endüstriyel temizlik gibi birçok alanda değerlendirilmesi planlanıyor. ÇOMÜ’lü akademisyenler, bu patentin Türkiye’nin yeşil teknolojilerdeki uluslararası görünürlüğünü artıracağını vurguluyor.